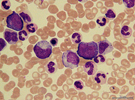
Blutausstrich_CML_presse_small

SPERRFRIST beachten: Montag, 7. Nov. 2016, 22:00 (7 Nov 2016, 4 p.m. Eastern Time, US)
Neuer Biomarker als innovatives Instrument für die Präzisionstherapie bei Leukämie
- Fortschritt in der Präzisionsmedizin
- Individualisierte Therapie noch gezielter steuern
- L-Selektin (CD62L) ist erster valider Biomarke
Der Einsatz moderner Targeted-Drugs bei der Bluterkrankung Chronische myeloische Leukämie (CML) gilt als Paradigma erfolgreich praktizierter, gezielter Krebstherapie. Mit der Identifizierung eines neuen Biomarkers gelingt Innsbrucker Krebsforschern nun ein weiterer Fortschritt in der Präzisionstherapie. Der neue immunologische Marker L-Selektin (CD62L) erlaubt schon zum Zeitpunkt der Diagnose eine Prognose über die Aggressivität der CML und das individuelle molekulare Ansprechen auf die Therapie. Dem Ziel, schon vor Therapiestart jene Patient:innen identifizieren zu können, bei denen die bisherige Dauertherapie erfolgreich abgesetzt werden kann, kommt man damit entschieden näher.
Innsbruck, 07.11.2016: Die zur Gruppe der Myeloproliferativen Neoplasien zählende Chronische Myeloische Leukämie (CML) resultiert aus einer genetischen Störung hämatopoetischer Stammzellen. An CML erkranken pro Jahr europaweit rund 6.500 Menschen neu. Mit Tyrosinkinase-Inhibitoren (TKI), dem medikamentösen „Goldstandard“ der CML-Behandlung, konnte die Lebenserwartung von CML-Patient:innen der von Gesunden inzwischen nahezu angeglichen werden. Die Schattenseite der Therapie zeigt sich in Nebenwirkungen der Dauertherapie, zumal die Medikamente nach bisherigem Kenntnisstand lebenslang eingenommen werden müssen. Seit kurzem weiß man, dass ein Teil der Patient:innen – jene, die molekular besonders gut ansprechen – die Medikamente schließlich absetzen und damit therapie- und nebenwirkungsfrei leben kann.
Therapieentscheidende Erkenntnis
Hier setzt die aktuelle, im hochrangigen Fachmagazin Journal of Clinical Oncology veröffentlichte Forschungsarbeit von Sieghart Sopper und Dominik Wolf an, die gemeinsam mit Günther Gastl, dem Direktor der Univ.-Klinik für Innere Medizin V (Hämatologie und Onkologie) an der Medizinischen Universität Innsbruck einen neuen Biomarker für die Aggressivität der CML und das Ansprechen auf die CML-Behandlung identifizieren konnten. „Anhand eines umfassenden, zentral an der Innsbrucker Univ.-Klinik für Hämatologie und Onkologie durchgeführten Monitorings von Blutproben aus ganz Europa und anschließender Validierung der Daten an deutschen und australischen Kohorten konnte die Forschergruppe nachweisen, dass CML-Patient:innen mit hohen löslichen CD62L-Spiegeln eine aggressive Verlaufsform aufweisen. „Dies ist wahrscheinlich Folge eines hoch entzündlichen Tumormikromilieus, was mit einem schlechteren molekularen Ansprechen auf die Therapie verbunden ist“, erklärt Sieghart Sopper, der in Innsbruck u.a. die Arbeitsgruppe Tumorimmunologie leitet.
Mit dem neuen immunologischen Biomarker CD62L (L-Selektin) steht der modernen Krebsbehandlung nun ein innovatives Instrument für eine zielgenauere Therapiewahl zur Verfügung.

Bild: Durch die Therapie mit Tyrosinkinaseninhibitoren (TKI) werden die
leukämischen Zellen abgetötet. Ziel ist es, die Zahl der entarteten Zellen
unter die Nachweisgrenze (tiefe molekulare Remission, TMR) zu bringen (B),
was nur bei einem Teil der Patienten gelingt (C, Remission unter Therapie).
Bei diesen Patienten kann nach einigen Jahren sogar im Rahmen von klinischen
Studien die Therapie abgesetzt werden, wobei etwa die Hälfte auch nach Jahren
ohne Rückfall bleibt (Therapie freie Remission).
Valider Biomarker mit Mehrwert
„Zwar wurden auch bislang auf klinischen Parametern basierende Risiko-Scores für die Therapiewahl herangezogen, doch valide Biomarker waren rar“, weiß Hämatologe Dominik Wolf, der in Innsbruck und Bonn bereits seit vielen Jahren zu Leukämie-Erkrankungen forscht und am Universitätsklinikum Bonn den Forschungsbereich Tumorimmunologie und als stellvertretender Klinikdirektor das myeloische Forschungsprogramm und den Bereich Knochenmarkstransplantation leitet. „Mit der neuen Erkenntnis wird es möglich sein, Patient:innen mit einer schlechteren Prognose von Beginn an mit wirksameren Substanzen oder Substanzkombinationen zu behandeln, um letztlich die Tumorlast so weit zu reduzieren, dass nach einiger Zeit die Therapie erfolgreich abgesetzt werden kann.“ Das Potenzial des Markers soll nun in weiteren malignen Bluterkrankungen, wie den Philadelphia Chromosom-negativen Myeloproliferativen Neoplasien und Myelodysplastischen Syndromen getestet werden.
Der aktuelle Forschungserfolg gelang im Rahmen eines Konsortiums von Forscher:innen aus Österreich, Holland und Finnland, welches, eingebettet in die ENEST1st-Studie, noch zahlreiche weitere Forschungsfragen und Projekte bearbeitet. „Er ist ein weiterer Beleg für den wachsenden Stellenwert eines umfassenden Immunmonitorings im Bereich der Hämato-Onkologie. Die Beteiligung an einer Vielzahl von internationalen klinischen Studien zeigt zudem, dass die Innsbrucker-Bonner Forschungsgruppe mit an der Spitze dieser Entwicklung steht“, kommentiert Klinikdirektor Günther Gastl das Ergebnis.
Weiterführende Links:
Link zur Forschungsarbeit im J Clin Oncol (aktiv ab 22:00 MEZ bzw. 4 p.m. Eastern Time, US)
http://ascopubs.org/doi/abs/10.1200/JCO.2016.67.0893
ENEST-First-Studie
http://www.nature.com/leu/journal/v30/n1/full/leu2015270a.html
Weitere Veröffentlichung im Rahmen des Konsortiums:
http://clincancerres.aacrjournals.org/content/22/16/4030.long
Univ.-Klinik für Innere Medizin V
https://www.i-med.ac.at/patienten/ukl_inneremedizin5.html
AG Tumorimmunologie / Priv.-Doz. Dr. Sieghart Sopper
http://www.haematologie-onkologie.at/de/wissenschaft-forschung.html
Uniklinikum Bonn / Prof. Dr. Dominik Wolf
http://www.ukb.uni-bonn.de/42256bc8002af3e7/vwwebpagesbyid/A17E8F2AA640820FC125793C00559987
PR & Medien
Pressebilder zum Herunterladen:

Die Autoren der Studie, v.l.: Univ.-Prof. Dr. Günther Gastl, Prof. Dr. Dominik Wolf und PD DR. Sieghart Sopper. (c) reimoschaaf.de
Bei der chronisch myeloischen Leukämie (CML) kommt es zu einer starken Vermehrung von bestimmten entarteten weißen Blutkörperchen. (c) Dominik Wolf

Durch die Therapie mit Tyrosinkinaseninhibitoren (TKI) werden die leukämischen Zellen abgetötet. Ziel ist es, die Zahl der entarteten Zellen unter die Nachweisgrenze (tiefe molekulare Remission, TMR) zu bringen (B), was nur bei einem Teil der Patienten gelingt (C, Remission unter Therapie). Bei diesen Patienten kann nach einigen Jahren sogar im Rahmen von klinischen Studien die Therapie abgesetzt werden, wobei etwa die Hälfte auch nach Jahren ohne Rückfall bleibt (Therapie freie Remission). (c) Wolf Sopper
Für Rückfragen:
Priv.-Doz. Dr. Sieghart Sopper
Universitätsklinik für Innere Medizin V
Tel.: +43 50 504 26332
E-Mail: Sieghart.Sopper@i-med.ac.at
Prof. Dr. Dominik Wolf
Medizinische Klinik und Poliklinik III Abteilung für Onkologie,
Hämatologie, Immunonkologie und Rheumatologie
Tel.: +49 (0)228 287 17233
E-Mail: dominik.wolf@ukb.uni-bonn.de
Medienkontakt:
Mag.a Doris Heidegger
Medizinische Universität Innsbruck
Abteilung für Öffentlichkeitsarbeit
Innrain 52, 6020 Innsbruck, Austria
Telefon: +43 512 9003 70083, Mobil: +43 676 8716 72083
public-relations@i-med.ac.at, www.i-med.ac.at